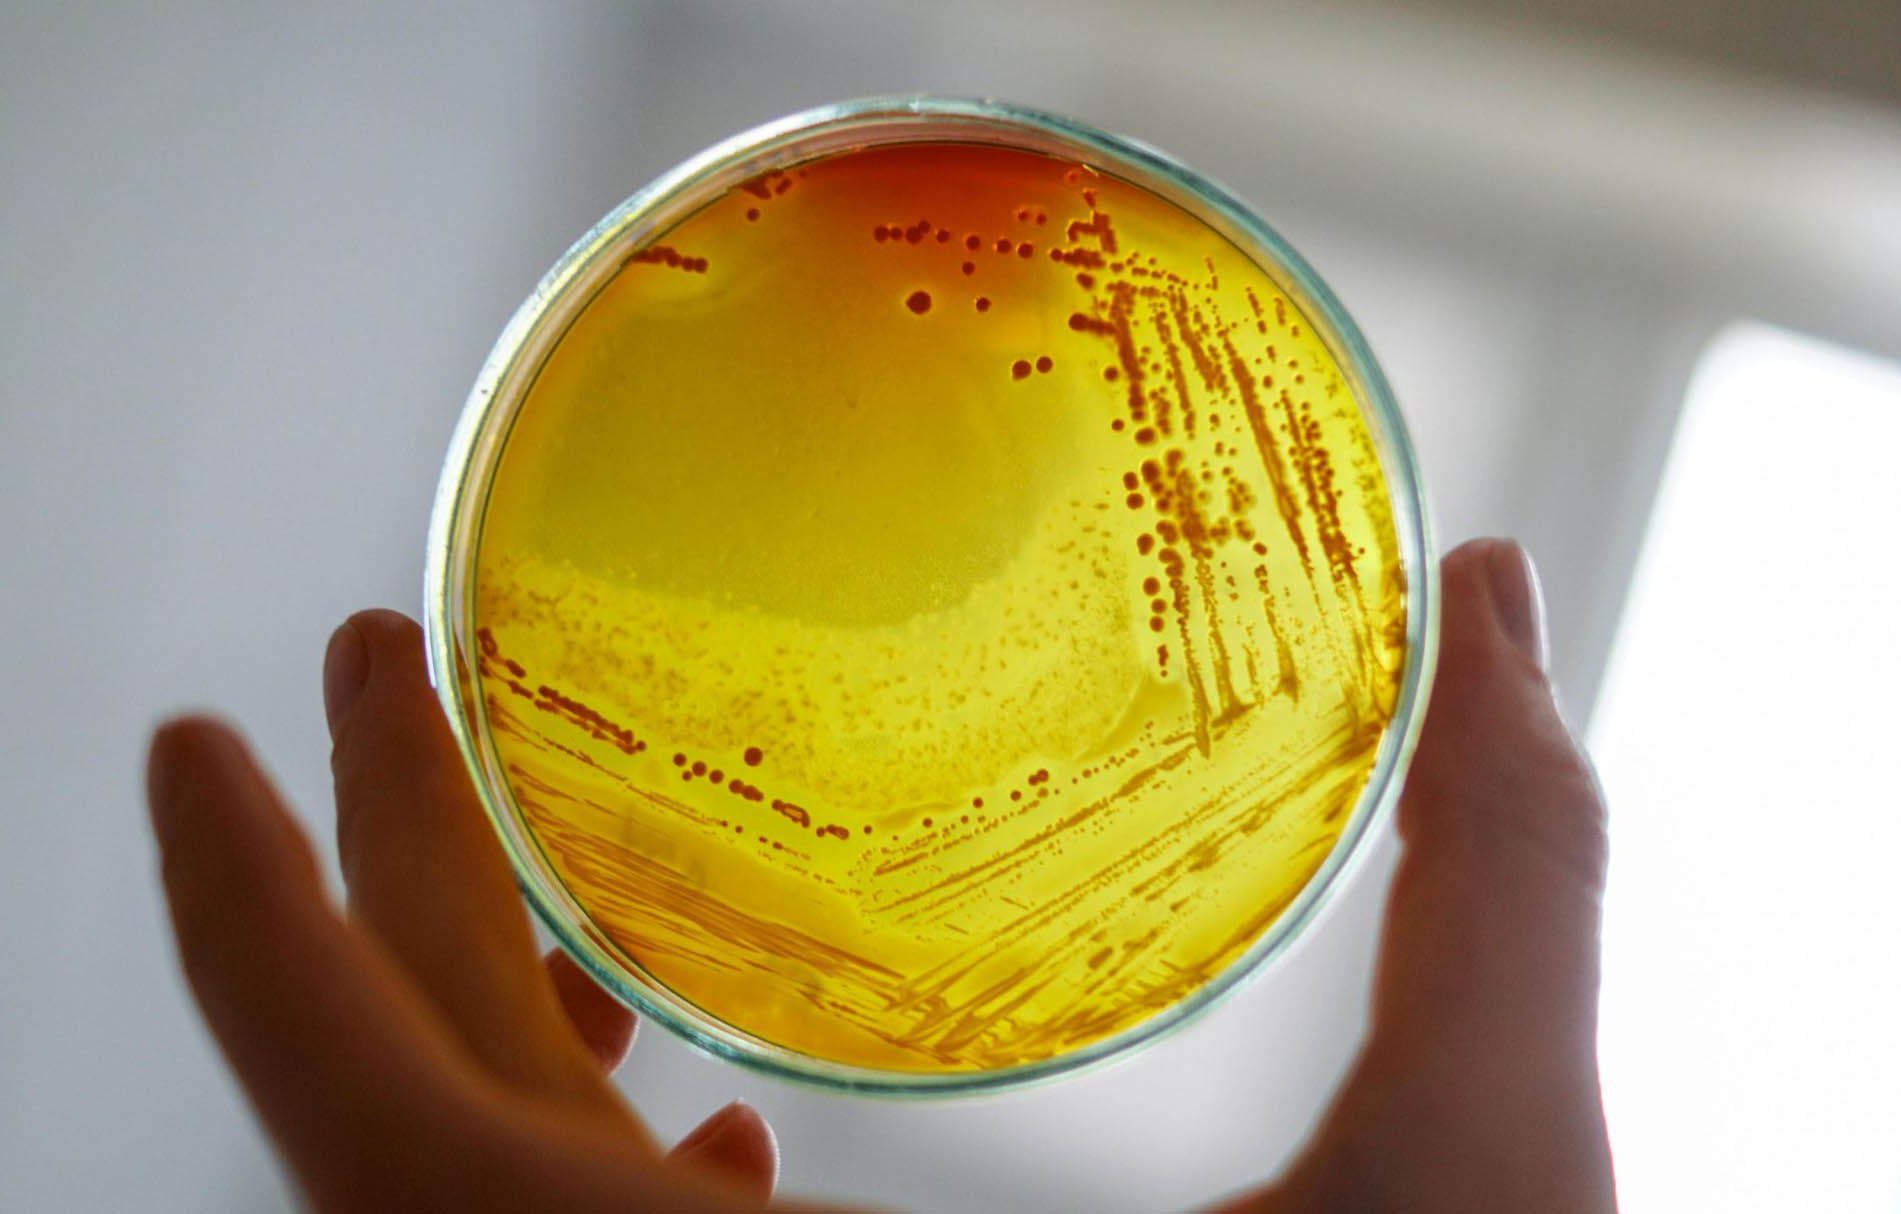
Bioinsumos de Nunatak en Expoagro en espacio Agtech

Bioinsumos de Nunatak en Expoagro en espacio Agtech
El Gobierno de la Ciudad de Buenos Aires, a través del Ministerio de Desarrollo Económico, participará con un stand oficial en Expoagro 2026 edición YPF Agro que se realizará del 10 al 13 de marzo en el predio ferial y autódromo de San Nicolás.
En esta edición, la Ciudad presentará una propuesta integral orientada a visibilizar y potenciar startups AgTech que forman parte de su ecosistema emprendedor, consolidando su posicionamiento como polo de innovación aplicada al sector productivo.
Durante los cuatro días de la muestra, el stand funcionará como espacio estratégico de exhibición, vinculación y generación de oportunidades de negocio. Catorce startups participarán en formato rotativo, presentando soluciones tecnológicas vinculadas a bioinsumos, monitoreo inteligente, energías renovables, biotecnología, software de gestión agropecuaria, economía circular y agricultura regenerativa. Asimismo, el espacio institucional contará con una sala de reuniones para facilitar encuentros estratégicos y fomentar la articulación público-privada.
Entre las empresas que participarán se encuentran desarrollos como tecnologías de microencapsulación para bioinsumos, plataformas de monitoreo postcosecha con sensores IoT e inteligencia artificial, soluciones de energía solar integradas para entornos rurales, herramientas digitales para la gestión de maquinaria pesada y propuestas biotecnológicas orientadas a mejorar la productividad y resiliencia de cultivos.
La agenda además incluirá actividades abiertas al público y al ecosistema productivo. El martes 10 de marzo a las 17 h, se realizará la presentación del libro digital “Mujeres en el Campo”, a cargo de Carlos Becco, referente del ecosistema AgTech y especialista en innovación y transformación digital en el agro.
El jueves 12 de marzo a las 17 h, tendrá lugar el panel “AgroTech: donde el capital siembra futuro”, un espacio de reflexión sobre inversión e innovación en el agro, con la participación de Innventure, inversores y startups del sector. La jornada cerrará con un After Emprendedor, pensado como instancia de networking para emprendedores, inversores y referentes de la industria.
La participación en Expoagro 2026 reafirma el compromiso de la Ciudad con el desarrollo productivo, la innovación tecnológica y el fortalecimiento del ecosistema emprendedor, promoviendo la conexión entre el talento urbano y los sectores estratégicos de la economía nacional.
Powered by Froala Editor

